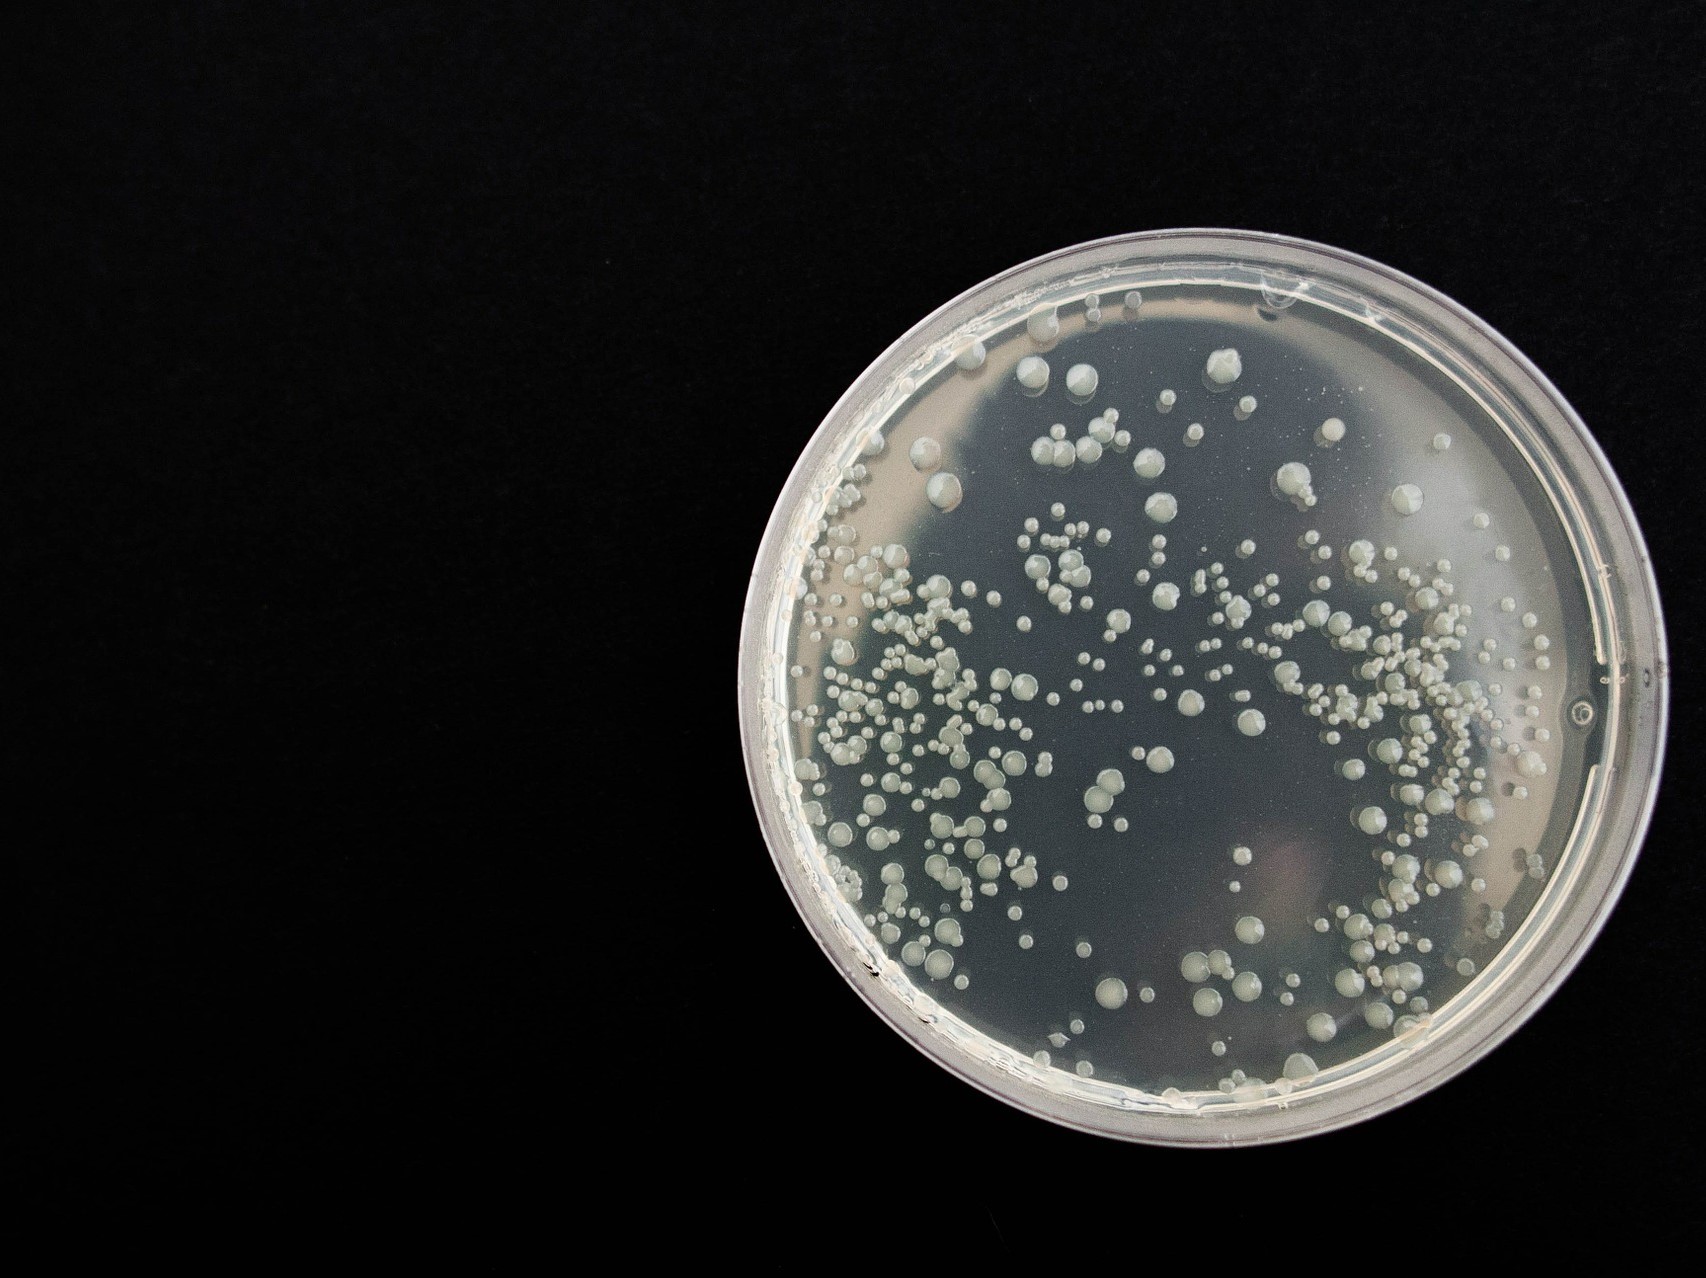

In de voedingsmiddelenindustrie wordt veel aandacht besteed aan reiniging en desinfectie. Maar reinigen alleen is niet voldoende. Bij reiniging en desinfectie wordt water gebruikt en water is de broedplaats van schimmels, virussen en bacteriën. Wanneer oppervlakken na het schoonmaken niet goed worden gedroogd, is het schoonmaakwerk eigenlijk voor niets geweest.
Snel drogen na reiniging doet Listeria meer afsterven
Onderzoek van de Universiteit van Dijon (Frankrijk) heeft aangetoond dat het sterftecijfer van Listeria monocytogenes in vier dagen toeneemt van gemiddeld Log 2,5 met alleen reiniging en desinfectie tot > Log 7 met reiniging, desinfectie en snel drogen door een luchtdroger (Log = tijd die de bacterie nodig heeft om zich te vermenigvuldigen). Zie figuur 1.
De hogere sterfte van Listeria is het gevolg van de zogenaamde waterstresscyclus, die uit de volgende drie stappen bestaat: osmotische stress (het vocht wordt aan de cel onttrokken) -> rehydra-tiestress (na het drogen neemt de cel weer water op) -> oxidatieve stress. Herhaald drogen en rehydrateren verzwakken de celwand, waardoor de cel vaker aan zuurstof wordt blootgesteld.

Wateractiviteit
Reinigings- en desinfectiemiddelen hebben een beperkte werkingsduur. Als ze uitgewerkt zijn en de gereinigde oppervlakken nog nat zijn, kunnen micro-organismen en ziekteverwekkers opnieuw gaan groeien. De micro-organismen zullen dus overleven, zich vermenigvuldigen en uiteindelijk zelfs een biofilm vormen die beter bestand is tegen de meeste reinigingsmiddelen. Drogen na het schoonmaken is daarom essentieel.
Relatieve vochtigheid
Ook de beheersing van de relatieve vochtigheid tijdens de productie is van cruciaal belang. Bij een hoge relatieve vochtigheid zullen sommige bacteriën (zoals Listeria) zich zelfs bij lage temperaturen nog vermenigvuldigen. Micro-organismen in productie- en opslagruimten kunnen het best onder controle worden gehouden door ze na reiniging en desinfectie snel te drogen en door de luchtvochtigheid tijdens de productie te regelen. De meeste ziekteverwekkers en virussen hebben gemeen dat zij slecht gedijen bijeen relatieve luchtvochtigheid van ongeveer 50-60%.
Een bijkomend voordeel van zo'n lage luchtvochtigheid is dat onderhoud aan gebouwen en apparatuur minder vaak nodig is en materialen en (elektronische) apparatuur minder snel slijten. Ook is het voor mensen veel aangenamer om in een drogere atmosfeer te werken.
Sorptiedrogers
Voor een droog en daardoor hygiënisch productieklimaat kunnen bijvoorbeeld die sorptiedrogers van het Zweedse bedrijf Munters een oplossing zijn. Dit bedrijf is gespecialiseerd in ontvochtigingssystemen voor de voedingsmiddelen- en farmaceutische industrie. De basis van hun droogmiddelontvochtigers wordt gevormd door een gepatenteerd droogwiel (zie afbeelding). Het vocht in de instromende proceslucht wordt afgegeven aan het droogmiddel in het wiel, waarna droge lucht uitstroomt. Een tweede, verwarmde luchtstroom (de zogenoemde reactivatielucht) droogt het materiaal in het wiel en voert het vocht af.
Dit artikel is tot stand gekomen in samenwerking met Munters.